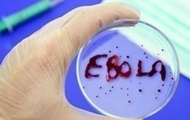

Новая вспышка Эболы в Африке рискует стать масштабнее эпидемии 2014 года, - ВОЗ
Опасный вирус уже вышел за пределы Конго Количество подтвержденных случаев заболевания Эболой в результате масштабной вспышки в Восточной Африке стремительно растет и уже вскоре достигнет отметки в 500 человек. rbc.ua »